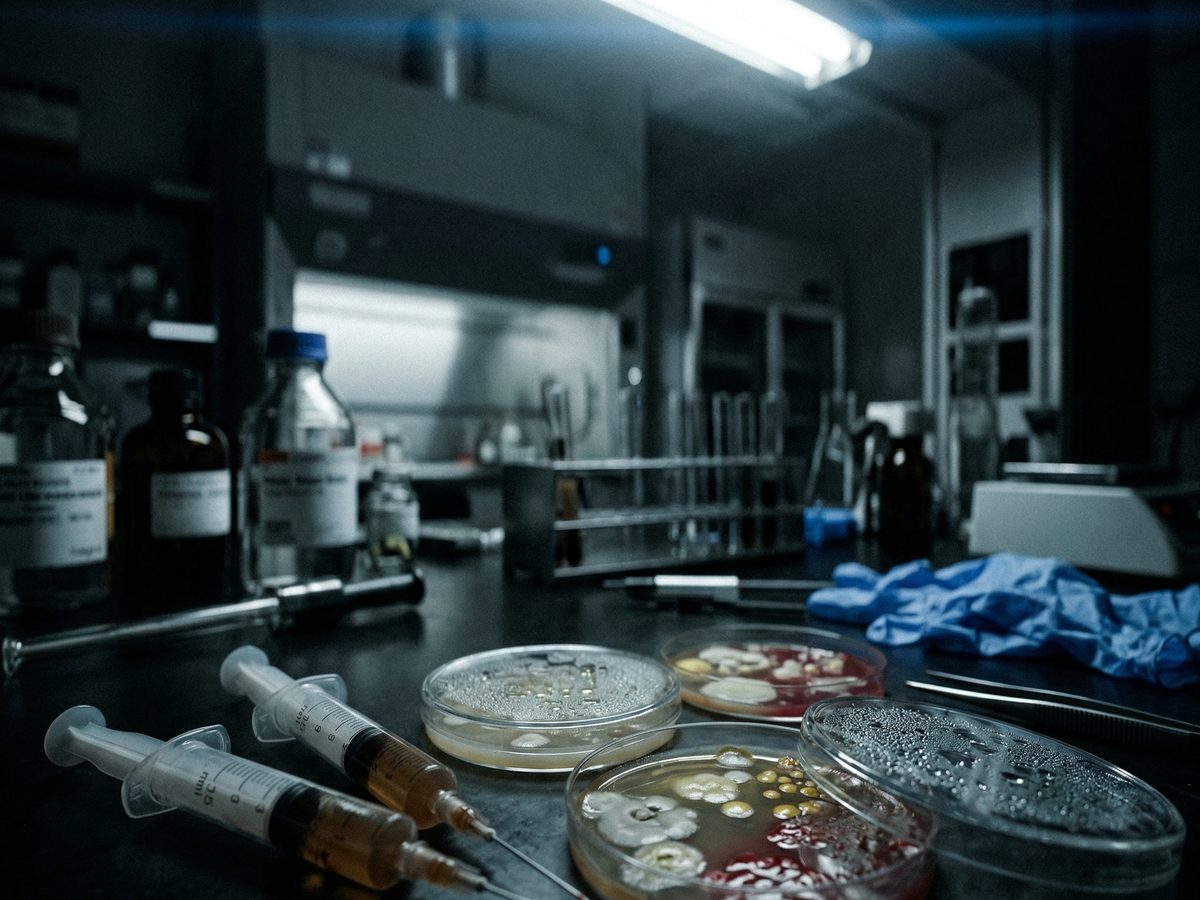
Kontaminierte medizinische Spritzen neben bakteriellen Kulturplatten unter Laborlicht

Am 26. Dezember 2025 starb ein 28-jähriger ehemaliger brasilianischer Fisiculturismo-Landesmeister namens Kevin Notário Nunes de Oliveira im Hospital Regional de Ponta Porã, Mato Grosso do Sul. Sein Vater, der Stadtrat Marcelino Nunes, bestätigte den Tod öffentlich. Die Diagnose laut Globo-Berichterstattung und infomoney.com.br: nekrotisierende Fasziitis, sogenannte “bactéria devoradora de carne”, ausgelöst durch die Injektion von Muskelaufbau-Produkten (G1/Globo MS Bericht).
Dieser Fall ist nicht der erste und nicht der letzte seiner Art, aber er ist so solide dokumentiert, dass er als Einstieg in ein medizinisches Thema taugt, das in der Forum-Welt eher geflüstert als besprochen wird. Dieser Artikel wertet zehn peer-reviewed PubMed-Publikationen der Jahre 2016 bis 2024 aus und verknüpft sie mit dokumentierten Einzelfällen. Das Ziel ist kein Angstartikel, sondern eine nüchterne Datenlage: Was genau geht bei kontaminierten UGL-Injektionen klinisch schief, welche Mechanismen sind belegt, und wie sieht die Prävalenz in den wenigen verfügbaren Surveillance-Studien aus?
Lokale Infektion: Staphylococcus aureus und der Weg in die Nekrose
Der Paradefall für die klinische Folge unsteriler Selbstinjektion ist der 2016 publizierte Case Report eines 35-jährigen Amateur-Bodybuilders, dokumentiert von Friedman, Arad und Ben Amotz im Journal Plastic and Reconstructive Surgery Global Open (PMC5055016, PMID 27757350, DOI 10.1097/GOX.0000000000001040). Der Patient hatte sich Trenbolon aus dem Schwarzmarkt beidseitig intragluteal injiziert. Innerhalb weniger Tage entwickelten sich bilaterale Nekrose-Areale: links 5 mal 4 Zentimeter, rechts 6.5 mal 4 Zentimeter, mit eitrigem Sekret und einer volldicken Gewebezerstörung, die bis in den Musculus gluteus maximus reichte.
Die Wundkulturen zeigten Staphylococcus aureus. Die Therapie bestand in chirurgischem Debridement, Mafenidacetat-Spülung und Heilung per sekundärer Wundgranulation über zwei Monate. Der Patient lehnte Hauttransplantationen ab. Der Originaltext formuliert den Rang dieses Befunds klar: “First documented case of full-thickness skin and subcutaneous tissue necrosis after black market anabolic steroid injection.” Also halt der erste publizierte Fall dieser Schwere. Dass es der erste war, heisst nicht, dass die Mechanik selten ist. Sie ist nur selten peer-reviewed dokumentiert, weil Case Reports zu typischen Komplikationen kaum publikationsfähig sind.
Was diesen Fall exemplarisch macht, ist die Kette. Unsterile Technik plus kontaminiertes Produkt plus ein maximal durchbluteter Injektionsbereich. Daraus bewegt sich Staph aureus durch die Faszien-Ebenen. Von dort sind zwei Eskalations-Wege dokumentiert: die klassische Weichteilinfektion mit Abszess und, im ungünstigen Fall, die nekrotisierende Fasziitis mit hoher Letalität. Notário Nunes bildet den zweiten Pfad ab. Friedmans Patient bildet den ersten, mit rechtzeitiger chirurgischer Intervention.
Lokale Infektionen sind aber nur ein Teil des Bildes. Wer Equipment teilt, riskiert zusätzlich eine ganz andere Kategorie von Schäden.
Bloodborne Viruses: Die 10-fache HCV-Prävalenz aus dem UK-Surveillance
Neben akuter Wundinfektion adressiert die Literatur eine zweite Infektionsschiene, nämlich chronische Virustransmission über gemeinsam genutztes Equipment. Eine zentrale europäische Datenquelle dafür ist eine UK-Surveillance-Studie, publiziert von Hope et al. 2017 in Drug and Alcohol Dependence (DOI 10.1016/j.drugalcdep.2017.06.018, PMID 28759821). Die Autoren werteten Daten von 564 IPED-injizierenden Personen aus England und Wales aus (2012 bis 2015), gewonnen über einen biobehavioralen Survey mit anonymen Trockenblut-Proben.
Die Kernzahlen gemäss Hope-Publikation sind deutlich. 4.8 Prozent Anti-HCV-Prävalenz im gesamten Kollektiv. Median-Alter: 31 Jahre, fast ausschliesslich männlich.
Entscheidend ist die Aufschlüsselung nach Polykonsum. Wer nur AAS spritzte, kam auf 1.4 Prozent HCV-Prävalenz. Wer zusätzlich psychoaktive Substanzen injizierte, lag bei 39 Prozent (p < 0.001). Das ist keine statistische Grauzone. Das ist ein 28-facher Unterschied zwischen zwei Gruppen, die sich nur in einer Variable unterscheiden.
Die zweite Hope-Arbeit desselben Teams, dokumentiert von Glass et al. 2019 in Drug and Alcohol Dependence (DOI 10.1016/j.drugalcdep.2018.11.021, PMID 30580202), beleuchtet den Versorgungsmechanismus. Von 467 IPED-Injizierenden, die ein Needle-Syringe-Programm besucht hatten, sammelten 34 Prozent Equipment für andere. Die Verteilung hinter der Sekundärdistribution war aufschlussreich: 55 Prozent sammelten für eine weitere Person, 27 Prozent für zwei bis neun, 5 Prozent für zehn bis neunzehn, und 13 Prozent für zwanzig oder mehr Personen.
Was die 13 Prozent zeigen, ist nicht ein individueller Harm-Reduction-Effekt, sondern eine informelle Infrastruktur. Ein aktiver Sammler in einer Gym-Clique versorgt zwanzig oder mehr Trainingspartner mit Equipment. Solange dieses Equipment neu ist, funktioniert das. Sobald ein Zwischenschritt im Sharing-Netzwerk rutscht, läuft die Viruslast durch das ganze Netz. Die Australian-Daten von Van de Ven et al. 2018 (DOI 10.1111/dar.12831, PMID 29968372) bestätigen das Muster aus einer anderen Hemisphäre: Ohne psychoaktive Drogen niedrige Viruslast, mit Polykonsum Explosion.
Infektionen und Virusübertragung sind die akuten Risiken. Die langfristigen Schäden spielen sich dagegen im Herz-Kreislauf-System ab.
Sudden Cardiac Death: Der häufigste dokumentierte Todesmechanismus
Der medizinisch härteste Review zum Thema stammt von Torrisi et al., publiziert 2020 in der Zeitschrift Medicina (Kaunas) (DOI 10.3390/medicina56110587, PMID 33158202, 104 Zitationen). Die Autoren werteten PubMed Central und Google Scholar bis Juli 2020 systematisch nach Fällen von Sudden Cardiac Death im Kontext von AAS-Missbrauch aus.
Die Kernaussage der Arbeit ist unbequem. Sudden Cardiac Death ist laut Torrisi et al. die häufigste medizinische Todesursache bei Sportlern generell, und der Einsatz von Performance-Enhancing-Drugs ist in diesen Statistiken überrepräsentiert. Bei AAS-Usern spezifisch identifiziert die Review drei zentrale Mechanismen: direkte Kardiomyozyten-Toxizität, elektrische Instabilität durch Hypertrophie und Fibrose sowie frühzeitige koronare Atherosklerose durch Lipidprofil-Verschiebung. Die Autoren rekonstruieren aus publizierten Fällen ein pathophysiologisches Modell, das erklärt, warum SCD in dieser Population schon in der dritten Lebensdekade auftreten kann.
Ein exemplarischer Einzelfall aus derselben Literatur ist der Melhem-Case-Report 2020 im American Journal of Case Reports (DOI 10.12659/AJCR.924796, PMID 32848124). Ein 26-jähriger brasilianischer Amateur-Bodybuilder erlitt während einer laufenden AAS-Kur einen Killip-Class-I-STEMI in der Vorderwand. Die klinische Pointe: Wenige Tage vor dem akuten Ereignis hatte er Lipid- und Hormonwerte messen lassen, die bereits drastisch erhöht waren. Trotz erfolgreicher Angioplastie der Left Anterior Descending blieben signifikante EKG-Sequelae und eine messbare ventrikuläre Dysfunktion.
Drei kurze Sätze zur Einordnung. 26 Jahre. Erster Herzinfarkt. Dokumentierte Lipid-Explosion vor dem Ereignis. Der Fall zeigt, dass die Vorhersagezeichen messbar sind, der Ausfall aber trotzdem geschieht. Das macht die klinische Lehre aus diesem Fall härter, nicht weicher: Ein Bluttest allein verhindert den Infarkt nicht, er dokumentiert nur, dass er zu erwarten war.
Doch selbst wenn ein solcher Tod eintritt, ist damit noch nicht gesagt, dass er korrekt dokumentiert wird. Das nächste Problem liegt in der Pathologie.
Forensische Autopsie: Warum ein Todesfall oft unterdiagnostiziert bleibt
Wenn ein Todesfall bei einem Trainierenden mit AAS-Hintergrund auftritt, ist der Weg zur korrekten Todesursache selten gradlinig. Esposito et al. 2021 veröffentlichten in Diagnostics (Basel) einen systematischen Review und ein forensisches Protokoll speziell für Post-Mortem-Untersuchungen bei AAS-Usern (DOI 10.3390/diagnostics11081307, PMID 34441242). Der Review erfasste AAS-bezogene Todesfälle zwischen Januar 1968 und Juni 2021 via PubMed und Google Scholar.
Das von den Autoren vorgeschlagene Protokoll hat drei Säulen: komplette Autopsie, histologische Analyse aller Zielorgane (Herz, Leber, Niere, Nebennieren, Gehirn) und eine breite toxikologische Untersuchung, die über Standard-Screenings hinausgeht. Der praktische Hintergrund für dieses Protokoll ist, dass AAS-Missbrauch in der Toxikologie nicht als Todesursache, sondern als Kontext erscheint. Ein 30-jähriger Bodybuilder mit SCD kann in einer schnellen Autopsie als “Herzinfarkt aus unklarer Ursache” klassifiziert werden, während ein methodisches Protokoll die Kardiomyopathie, die Lipidprofil-Anomalien und die Toxikologie-Muster zusammenführt und zur Diagnose “AAS-assoziierter Herztod” kommt.
Was dieser Review ungemütlich klar macht, ist die Dunkelziffer. Jeder Todesfall ohne methodisches Autopsie-Protokoll verschwindet in einer Statistik, in der die AAS-Komponente nicht benannt ist. Die offizielle Zahl der AAS-assoziierten Todesfälle liegt deshalb nach Einschätzung der Autoren systematisch unter dem realen Geschehen, und der Versuch, eine Punkt-Prävalenz anzugeben, scheitert an dieser Unterdiagnose.
Neben AAS gibt es eine weitere injizierbare Substanzklasse, die ein völlig eigenes Risikoprofil mitbringt und in keiner der bisherigen Kategorien aufgeht.
Synthol und die Öl-Embolie: Ein separates Risikoprofil
Nicht alle Injektions-Komplikationen stammen von AAS selbst. Eine eigene Fallgruppe betrifft sogenannte Site-Enhancer, vor allem Synthol, eine Öl-Mischung aus medium-chain-Triglyceriden, Lidocain und Benzylalkohol, die lokal zur optischen Muskelvergrösserung injiziert wird. Alimoradi et al. dokumentierten 2021 in Annals of Medicine and Surgery einen Case Report zu systemischen Synthol-Komplikationen mit Hyperkalzämie und pulmonaler Granulomatose (DOI 10.1016/j.amsu.2021.102771, PMID 34522373).
Die Mechanik ist bestechend einfach. Öl, das lokal eingebracht wird, migriert bei genügender Menge entlang von Faszien und in den venösen Rückfluss. In der Lunge lagert es sich in Kapillaren und im umliegenden Gewebe ab und löst eine chronische entzündliche Fremdkörper-Reaktion aus, die sich als Granulom darstellt. Die Hyperkalzämie folgt aus der aktivierten Makrophagen-Aktivität in den Granulomen, ein Muster, das aus der Sarkoidose bekannt ist und bei Synthol in einzelnen Fällen dokumentiert wurde.
Dass dieses Problem nicht auf ältere Fälle beschränkt ist, zeigt Nassar et al. in einer Arbeit von 2024 im Plastic and Reconstructive Surgery Global Open (DOI 10.1097/GOX.0000000000006391, PMID 39687419). Die Autoren beschreiben die operative Behandlung Synthol-induzierter Muskelfibrose, die sich chirurgisch oft nur partiell korrigieren lässt. Wer Synthol einmal im Deltamuskel oder Biceps hat, behält die Fibrose, selbst bei späterer operativer Intervention. Anders als die akute Sepsis bei Friedmans Trenbolon-Patient ist das keine Notfallsituation, sondern eine permanente strukturelle Schädigung.
Von einzelnen Case Reports zurück zum Gesamtbild: Wie ordnet die klinische Forschung alle diese Risiken systematisch ein?
Was die Vorona-Review über das gesamte Nebenwirkungs-Spektrum sagt
Die breiteste DACH-nahe Übersichtsarbeit stammt von Vorona und Nieschlag, publiziert 2018 in Minerva Endocrinologica (DOI 10.23736/S0391-1977.18.02810-9, PMID 29463075, 54 Zitationen). Eberhard Nieschlag ist ein Münsteraner Endokrinologe mit jahrzehntelanger Erfahrung in der Andrologie, und die Review fasst das Nebenwirkungs-Spektrum systematisch zusammen.
Die Arbeit gruppiert die Effekte in fünf Bereiche. Erstens: endokrinologische Schäden wie Hypogonadismus, Fertilitätsstörung und Gynäkomastie. Zweitens: Hepatotoxizität, vor allem durch orale 17-alpha-alkylierte Substanzen, mit dokumentierter Cholestase und Peliosis hepatis. Drittens: kardiovaskuläre Effekte als zentrale Mortalitätsursache. Viertens: psychiatrische Effekte einschliesslich Aggression, Depression und eines AAS-Abhängigkeitssyndroms. Fünftens: dermatologische und muskuloskelettale Komplikationen.
Was die Vorona-Review von einer Forum-Diskussion unterscheidet, ist die Gewichtung. Im Forum stehen Gynäkomastie und Akne als dominante Themen, weil sie sichtbar sind und schnell bereut werden. In der klinischen Literatur dominieren kardiovaskuläre und endokrinologische Schäden, weil sie die langfristigen Mortalitäts- und Morbiditätstreiber sind. Wer seine Risiken nach dem gewichtet, worüber im Forum am lautesten geschrieben wird, priorisiert falsch.
Damit steht das medizinische Gesamtbild: von der lokalen Staph-aureus-Infektion über die HCV-Schwelle bei Polykonsum bis zum plötzlichen Herztod. Was sich daraus für konkrete Verhaltensregeln ableiten lässt, zeigt der folgende Abschnitt.
Was die Datenlage für praktische Harm-Reduction bedeutet
Aus der hier ausgewerteten Literatur lassen sich fünf Linien ziehen, die sich direkt in Verhalten übersetzen, ohne dass dieser Artikel damit eine Empfehlung für den Konsum selbst abgibt. Der Grundsatz bleibt: Die einzige sichere Option ist die, es nicht zu tun. Wer sich entgegen dieser Option entscheidet, steht aber vor dokumentierbaren Risiken, die sich in ihrer Auftretenswahrscheinlichkeit stark unterscheiden.
Die erste Linie betrifft die Injektionstechnik. Der Friedman-Fall zeigt, dass der Weg von einer kontaminierten Injektion zu einer volldicken Gluteus-Nekrose innerhalb weniger Tage verläuft. Hygiene ist nicht Bequemlichkeit, sondern der entscheidende Unterschied zwischen einem benignen Kurs und einer chirurgischen Notfallsituation. Needle-Syringe-Programme in der Schweiz (z.B. via die kantonalen Suchtberatungen), in Deutschland (über Drogenberatungsstellen und teilweise Apotheken) und in Österreich liefern sauberes Equipment. Die UK-Daten von Glass et al. belegen, dass die Infrastruktur genutzt wird, aber mit einer Verteilmechanik, die in der Hand des Einzelnen rutschen kann.
Die zweite Linie betrifft Equipment-Sharing. Hope et al. zeigen die Dosis-Wirkungs-Kurve zwischen Polykonsum und HCV-Prävalenz. Der Sprung von 1.4 Prozent auf 39 Prozent ist keine graduelle Kurve, sondern eine Schwelle. Wer neben AAS psychoaktive Substanzen spritzt, lebt in einem anderen Infektionsuniversum als jemand, der ausschliesslich AAS selbst spritzt. Diese Trennung ist nicht moralisch, sondern epidemiologisch messbar.
Die dritte Linie betrifft die Bezugsquelle. Der Friedman-Case-Report benennt “Black Market” explizit im Titel. Der Zusammenhang zwischen unregulierter Produktion und Kontamination ist nicht spekulativ, sondern steht in der Publikation selbst. Der vorausgegangene Artikel dieser Serie zu Fake Reviews und Shilling liefert die Werkzeuge, um Bezugsquellen vor dem Kauf zu filtern, auch wenn diese Werkzeuge keine Sterilitätsgarantie geben.
Die vierte Linie betrifft Monitoring. Der Melhem-Fall zeigt eine dokumentierte Lipid- und Hormon-Explosion wenige Tage vor dem Herzinfarkt. Pre-, Mid- und Post-Cycle-Bluttests sind keine Ausrede für das Weitermachen, aber sie sind ein Datenpunkt, der Muster sichtbar macht. Wer seine Werte kennt und sie ernst nimmt, bekommt wenigstens die Chance, vor dem Ereignis zu handeln, wenn sich die Vorhersagezeichen häufen.
Die fünfte Linie betrifft den Zugang zu medizinischer Versorgung im Notfall. Das Paradox der UGL-Anwendung ist, dass eine illegale Substanz eine legale Klinik benötigt, sobald Komplikationen auftreten. Das Aufschieben einer Vorstellung wegen Scham oder Angst vor Konsequenzen ist in den dokumentierten Notfällen ein häufiger Faktor für Eskalation. In der Notaufnahme zählt die ehrliche Angabe der injizierten Substanz. Ohne diese Information dauert die Diagnose länger und die erste Antibiotika-Wahl trifft möglicherweise das falsche Spektrum.
Dokumentierte Komplikations-Gruppen bei UGL-Injektionen
Vier Gruppen, jeweils mit peer-reviewed Quelle und klinischem Mechanismus. Alle Details basieren auf den im Artikel verlinkten Publikationen.
Lokale Bakterielle Infektion
Unsterile Technik plus kontaminiertes UGL-Produkt. Leitpathogen Staphylococcus aureus, inkl. MRSA. Eskalation von Zellulitis ueber Abszess zu nekrotisierender Fasziitis.
- Typische Manifestation: Abszess oder Myositis am Injektionsort (i.d.R. gluteal)
- Therapie: chirurgisches Debridement plus gezieltes Antibiotikum
- Worst Case: Nekrotisierende Fasziitis mit hoher Letalitaet
Friedman 2016 PMID 27757350 (Trenbolon-Nekrose Case Report); Notario 2025 G1/Globo Dezember 2025 (Todesfall Brasilien).
Bloodborne Viren (HCV, HIV, HBV)
Transmission via gemeinsam genutztes Equipment. In UK-Surveillance zehnfach erhoehte Anti-HCV-Praevalenz gegenueber Allgemeinbevoelkerung.
- UK Daten 2012-15: 4.8 Prozent Anti-HCV Praevalenz (N=564)
- Bei Polykonsum (IPED plus psychoaktiv): 39 Prozent
- 34 Prozent der UK-IPED-User sammeln Equipment fuer andere
Hope 2017 PMID 28759821; Glass 2019 PMID 30580202; Van de Ven 2018 PMID 29968372.
Sudden Cardiac Death + Akuter MI
Haeufigste medizinische Todesursache in der AAS-Literatur. Mechanismen: direkte Kardiomyozyten-Toxizitaet, elektrische Instabilitaet, vorzeitige Atherosklerose.
- Torrisi-Review identifiziert 3 zentrale pathophysiologische Mechanismen
- Melhem 2020: 26-jaehriger Bodybuilder mit STEMI bei laufender Kur
- Esposito 2021: forensisches Protokoll, um Dunkelziffer zu reduzieren
Torrisi 2020 PMID 33158202; Melhem 2020 PMID 32848124; Esposito 2021 PMID 34441242.
Synthol: Oel-Embolie und Fibrose
Nicht AAS selbst, sondern Site-Enhancer. Oel migriert in Lunge, Granulom-Bildung mit Hyperkalzaemie, langfristige Muskelfibrose.
- Alimoradi 2021: systemische Komplikationen mit pulmonaler Granulomatose
- Nassar 2024: operative Korrektur der Fibrose oft nur partiell moeglich
- Schaden ist permanent, auch nach Absetzen
Alimoradi 2021 PMID 34522373; Nassar 2024 PMID 39687419.
So sind diese Daten entstanden
Die ausgewerteten Primärquellen umfassen zehn peer-reviewed Publikationen, gefunden via systematischer PubMed-Suche am 11. April 2026. Die Suchbegriffe waren “anabolic steroid injection abscess”, “anabolic androgenic steroid endocarditis”, “anabolic steroid sudden cardiac death”, “synthol complication”, “intramuscular steroid injection gluteal abscess” und “image and performance enhancing drugs injecting infection”, jeweils mit Mindestjahr 2015 oder 2018. Aufgenommen wurden systematische Reviews, narrative Reviews und primäre Arbeiten mit mindestens einem Zitationswert, die AAS-Komplikationen mit expliziten klinischen oder epidemiologischen Daten belegen.
Die News-Quelle zu Kevin Notário Nunes de Oliveira stammt aus der brasilianischen Mainstream-Presse (G1 Globo, Artikel vom 26. Dezember 2025) und aus infomoney.com.br vom 27. Dezember 2025, verifiziert über Fitness Volt und weitere englischsprachige Sekundärberichterstattung. Der Fall wurde als Einzelbelegs-News-Datenpunkt aufgenommen, weil er aktuell ist, mehrere unabhängige Quellen hat und mit einer klaren klinischen Diagnose (nekrotisierende Fasziitis) verknüpft ist.
Der Friedman-Case-Report 2016 dient als methodisch höchstwertiger Referenzfall für die lokal-infektiöse Komplikationsgruppe, weil er peer-reviewed, mit Kultur-nachweis des Pathogens und vollständigem klinischem Verlauf publiziert ist.
Limitationen, die ehrlich benannt gehören. Erstens: Dieser Artikel ersetzt keine medizinische Beratung, er fasst lediglich die publizierte Literatur zusammen. Zweitens: Case Reports sind per Definition Einzelfälle und keine Populations-Statistiken. Drittens: DACH-spezifische Case Reports zu UGL-Injektions-Komplikationen sind in der peer-reviewed Literatur unterrepräsentiert, Fälle aus Schweizer und österreichischen Kliniken werden seltener publiziert als US- und UK-Fälle. Viertens: Der Notario-Fall basiert auf Presse-Berichterstattung, nicht auf einem veröffentlichten Obduktions-Protokoll. Schuldfragen und detaillierte bakteriologische Befunde liegen zum Stand 11. April 2026 nicht in einer peer-reviewed Quelle vor.
Querverweis auf die vorausgehenden Artikel dieser Serie: UGL-Foren-Uebersicht Meso, Reddit, Lifters, Sponsored Sources und Bestechung, Fake Reviews erkennen und Lab-Skandale-Geschichte.




